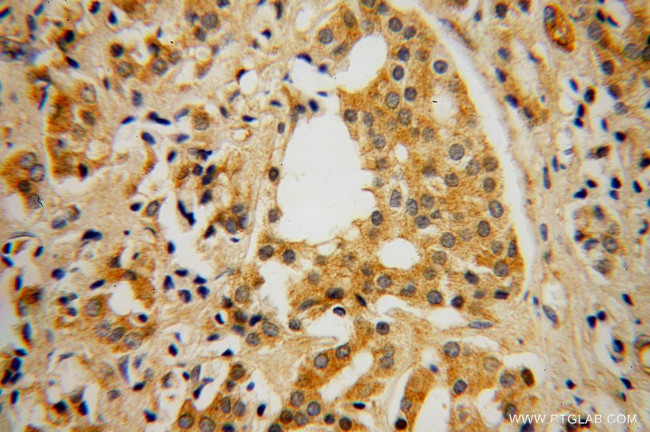
GBP5 Antibody in Immunohistochemistry (Paraffin) (IHC (P))

Search
Proteintech
GBP5 Polyclonal Antibody
{{$productOrderCtrl.translations['antibody.pdp.commerceCard.promotion.promotions']}}
{{$productOrderCtrl.translations['antibody.pdp.commerceCard.promotion.viewpromo']}}
{{$productOrderCtrl.translations['antibody.pdp.commerceCard.promotion.promocode']}}: {{promo.promoCode}} {{promo.promoTitle}} {{promo.promoDescription}}. {{$productOrderCtrl.translations['antibody.pdp.commerceCard.promotion.learnmore']}}








Please note: We are reviewing Western blot images included in the antibody testing data in our catalog, including those provided by third parties. Unless expressly labeled or annotated as “raw-unedited”, Western blot images included in the antibody testing data in our catalog may have been edited, optimized or otherwise adjusted for presentation.
产品信息
13220-1-AP
种属反应
已发表种属
宿主/亚型
分类
类型
抗原
偶联物
形式
浓度
规格
纯化类型
保存液
内含物
保存条件
运输条件
产品详细信息
Immunogen sequence: LETLLDAKQ NDICKRNLEA SSDYCSALLK DIFGPLEEAV KQGIYSKPGG HNLFIQKTEE LKAKYYREPR KGIQAEEVLQ KYLKSKESVS HAILQTDQAL TETEKKKKEA QVKAEAEKAE AQRLAAIQRQ NEQMMQERER LHQEQVRQME IAKQNWLAEQ QKMQEQQMQE QAAQLSTTFQ AQNRSLLSEL QHAQRTVNND DPCVLL (382-586 aa encoded by BC031639)
靶标信息
The guanylate-binding proteins (GBPs) are a family of interferon-induced GTP-binding proteins function in innate immunity against microbial and viral pathogens. In humans, there are seven GBPs from hGBP1 to hGBP7. Human GBP1 and GBP2 have been shown to exhibit antiviral activity as well as being able to regulate the inhibition of proliferation and invasion of endothelial cells in response to interferon (IFN). GBP5 promotes selective NALP3 inflammasome responses to pathogenic bacteria and soluble but not crystalline inflammasome priming agents.
仅用于科研。不用于诊断过程。未经明确授权不得转售。